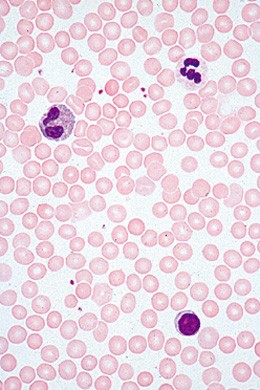

- Best.-Nr.: 400942
- Info zur LIeferzeit: Herstellerlieferung
Basispaket mit 6 Einheiten 1. Buchstabe ”e” 2. Musca domestica, Stubenfliege, Bein total.... mehr
Produktinformationen "Allgemeinwissen Mikroskopie Schülerpaket SSD-01"
Basispaket mit 6 Einheiten
1. Buchstabe ”e”
2. Musca domestica, Stubenfliege, Bein total. Haftballen
3. Pieris, Schmetterling, Stück vom Flügel mit Schuppen
4. Blut vom Menschen, Ausstrich.
5. Pflanzenzellen, Holundermark, quer
6. Farbige Textilfasern w.m.
6 Mikropräparate im Plastikkasten, Textheft mit Erläuterungen, Aufbewahrungskarton.
| Ausführung: | Präparateserie |
Bewertungen lesen, schreiben und diskutieren... mehr
Kundenbewertungen für "Allgemeinwissen Mikroskopie Schülerpaket SSD-01"
Bewertung schreiben
Bewertungen werden nach Überprüfung freigeschaltet.
Zuletzt angesehen